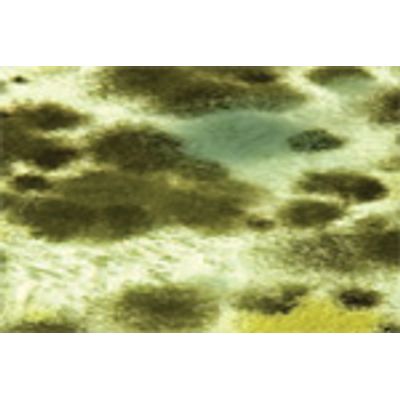

- Home
- Companies
- Environmental Waste Management ...
- Articles
- Mold and the Re-use of Demolition ...
Mold and the Re-use of Demolition Materials
ABATEMENT OF MOLD
While mold plays an important role in the ecosystem, exposure to too much or the wrong type of mold can have serious health effects. “Black mold” or Stachybotrys chartarum is a greenish-black mold which has been linked to respiratory problems, severe allergic reactions, and
even neurological impairment. Accordingly, identification and abatement of mold in existing buildings and the prevention of reoccurrence during construction and demolition is necessary to prevent adverse health consequences, maintain property values, and decrease construction defect claims.
The U.S. Environmental Protection Agency (EPA) and the majority of states have developed guidelines for remediation of mold in commercial buildings and schools. In many instances, mold inspections have become common components of most private party real estate transactions as banks and insurance companies have learned the hard financial lessons associated with not checking for its presence. Mold also has been linked to Sick Building Syndrome and building occupants have sued for damages related to mold growth that allegedly caused hair loss, dizziness, vertigo, abdominal pain, respiratory distress, tinnitus (ringing in the ear), facial swelling, and severe rashes.
An article by Kimberly Hicks, Assistant Project Manager, titled `Mold and the Re-use of Demolition Materials` appeared in the April 2010 edition of Modern Contractor Solutions magazine.
